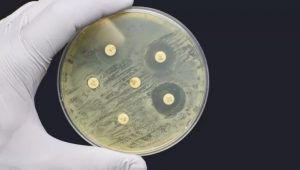

Гастроентеролог назвала продукти, які допоможуть підтримати організм людини під час прийому антибіотиків. За її словами, із цим можуть допомогти квашена капуста, а також солоні огірки.
«Поповнити дефіцит корисних бактерій допоможуть ферментовані продукти. Це доступні нам квашена капуста та солоні огірки», — заявила фахівець.
Вона додала, що корисні для здоров’я пробіотики.
Вони містяться у кисломолочних продуктах з малим терміном придатності. Лікар уточнила, що варто купувати продукти, які не містять цукру та ароматизаторів, а також без збагачення лактобактеріями.